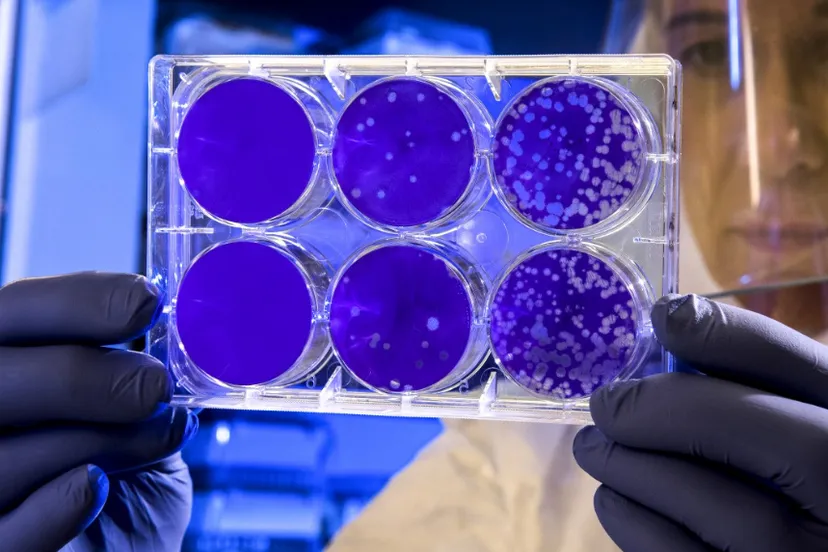
screenshot 20210819 143151

Wat uitglijder met Ornina gemeente kost blijft geheim
19 aug 2021, 15:12 • Bedrijvigheid

Facebook / Restaurant Ornina
De gemeente maakt niet bekend hoeveel Zaanstad uitbater Bassel Kurdi van restaurant Ornina aan het Kuilpad in Zaandam betaalt nadat hij bijna failliet ging door te hard ingrijpen van burgemeester Jan Hamming. Die trok zijn vergunning in na een aantal kleine onregelmatigheden, zoals muziek op het terras.
Over de geleden schade is nu een akkoord bereikt , schrijft Hamming aan de raad. Om de door Kurdi gewenste vergunning - die ook feesten en partijen mogelijk maakt in het horecapand - te kunnen verwerven heeft eigenaar Brevé Beheer BV eind juni opdracht gegeven voor een extern advies over parkeren en stikstof. Dat advies is nog nodig om te komen tot een aanvraag. Dat de vaststellingsovereenkomst over de schadevergoeding geheim is, is omdat daarvoor vertrouwelijke bedrijfsgegevens aan de gemeente ter beschikking zijn gesteld.
Unieke context
'De tegemoetkoming is opgebouwd uit geverifieerde bedrijfseconomische schadeprognoses. Die informatie en de daaraan ten grondslag liggende data zijn bedrijfsgegevens die vertrouwelijk aan de gemeente zijn verstrekt en derhalve geheimgehouden dienen te worden,' aldus Hamming. De gemeente wil met de overeenkomst ook zichzelf niet in de nesten werken: die is het resultaat van 'een afweging in een unieke context en geen standaard beleidsuitvoering'. Met andere woorden: niemand kan er met succes naar wijzen voor eigen gewin.
Loading articles...
Loading